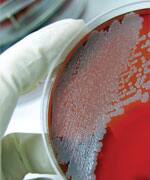
Probiotics And Chronic Disease

Life Extension Magazine®

Probiotics, the beneficial bacteria commonly found in yogurt cultures, are popularly thought of as an aid to good digestion. But scientists are discovering that probiotics and the resulting healthy balance of gut bacteria confer a broad spectrum of previously unrecognized health benefits.1
As we age, take antibiotics, or eat an unhealthy diet, the delicate balance between beneficial and bad gut bacteria becomes disrupted.2-4 Not having the proper balance of good-to-bad bacteria can wreak havoc throughout the body as well.5-9
For instance, scientists have discovered that an imbalance of healthy gut bacteria plays an important role in the development of chronic conditions such as autoimmune disorders, metabolic syndrome, diabetes, obesity, chronic fatigue syndrome, and non-alcoholic fatty liver disease (NAFLD).5-11
So while supplementing with good bacteria has been seen as providing defense primarily against intestinal conditions—such as inflammatory bowel disease (IBD), irritable bowel syndrome (IBS), and colon cancer—scientists now believe that they help prevent many of the diseases of aging as well.6,7,9,11-13
Fortunately, evidence demonstrates that supplementing with the right mix of probiotic bacteria such as Lactobacillus and Bifidobacterium species can powerfully ward off many of the factors leading to chronic disease.12 Probiotics can restore your body’s natural, intestine-based protection against a host of non-intestinal diseases and shield you from the diseases of aging.5-11
Total Body Benefits Of Balanced Gut Bacteria
It has long been known that certain types of beneficial gut bacteria:
- Help break down dietary residues (such as indigestible fibers) and synthesize vitamins;
- Limit pathogenic colonization within the gut, protecting our bodies from infections; and
- Play a crucial role in the immune system, an estimated 70-80% of which is located in and around the gut.14,15
But compelling new evidence indicates that good bacteria also play a beneficial role outside the digestive tract, delivering broad-spectrum protection throughout the body.5-11
For example, two of the most studied and proven groups of bacteria—Lactobacillus and Bifidobacterium —have been found to protect against diseases not normally associated with intestinal origins.16-18
Scientific studies have found associations between different species of Lactobacillus ( Lactobacillus acidophilus, Lactobacillus paracasei, and Lactobacillus rhamnosus) and increased HDL cholesterol, balanced immune response, and reduced markers of inflammation, respectively.16
Similarly, associations have been found between different Bifidobacterium species (Bifidobacterium lactis, Bifidobacterium bifidum, and Bifidobacterium longum) and improved blood sugar control, decreased liver inflammation, and reduced DNA damage that could trigger malignant cell development, respectively.16-18
How Intestinal Imbalance Affects The Entire Body

So why is it that an imbalance in gut bacteria affects areas of the body outside of the intestines?
The answer lies in the fact that the intestinal tract contains one of the highest concentrations of chemical detection and signaling molecules—molecules that affect cells throughout your entire body.15
Your intestinal bacteria produce proteins that have a powerful influence on these chemical detectors—and as with any influence, this one can be positive or negative.19 Over time, an imbalance in the ratio of good-to-bad bacteria activates many of these detectors in negative ways that can trigger the development of a host of diseases in many body areas—not just those associated with the gut.5-11
Fortunately, using probiotic supplements to restore a healthy balance to your gut bacteria can reverse these disruptions to intestine-based signaling mechanisms. This, in turn, reverses the negative influence that triggers the development of chronic disease.20
The Powerful Role Of Probiotics In Cancer
As an example, take just one deadly disease: cancer. Scientists have demonstrated that probiotic organisms switch on protective signaling mechanisms that:
- Suppress bacteria that convert pro-carcinogen molecules into carcinogens.21,22
- Bind to potential carcinogens, promoting their excretion.21
- Decrease enzymes implicated in the development of carcinogens.21
- Boost populations of immune cells that play a role in tumor inhibition.22,23
- Up-regulate immune cytokines to battle the early stage of cancer or other threats.22
- Suppress the inflammatory response as the cancer or infection threat fades.22,24
What You Need To Know
|
Probiotics And Chronic Disease
- Evidence shows that prolonged imbalance in intestinal bacteria can do more than induce intestinal diseases—it can trigger lethal diseases throughout the body!
- Properly balanced gut bacteria produce biologically active proteins that cross into the blood. In this way, “good bacteria” inhibit pathways of numerous chronic diseases—including obesity, diabetes, the metabolic syndrome, cardiovascular disease, cancer, and respiratory infections.
- Today’s diet, lifestyle, medical practices, and other factors tend to disrupt gut bacterial balance.
- Evidence shows that supplementing with key species restores the proper balance of beneficial bacteria—in turn restoring your body’s natural, intestine-based protection against a host of non-intestinal diseases!
Probiotics Protect Against Numerous Diseases
Experimental models and randomized, controlled human intervention studies have confirmed that taking a probiotic supplement to restore the balance of gut bacteria also restores natural protection against multiple diseases.25 Take a look:
Intestinal health. A popular use of probiotics is to improve intestinal health by increasing levels of beneficial bacteria.26,27 Lactobacillus and Bifidobacteria, two of the most studied types of beneficial bacteria, have been shown to support intestinal function and improve both diarrhea and constipation.28-30 Probiotic supplements have helped improve both the quality of life and symptoms of patients with functional bowel disorders such as irritable bowel syndrome (IBS) and ulcerative colitis, as well as those of generally healthy people.29,31-33
Diabetes and the metabolic syndrome. Lactobacillus and Bifidobacteria probiotics demonstrated improvement in insulin resistance and significant reductions in blood sugar concentrations in animal studies and human diabetes clinical trials.17,34-36 In a 6-week study of patients with type II diabetes, fasting glucose and hemoglobin A1c (a measure of long-term blood sugar control) were significantly improved through consumption of a probiotic yogurt containing Lactobacillus acidophilus and Bifidobacterium lactis; total antioxidant status also increased.17
Obesity. An association between antibiotic overuse and obesity has been demonstrated.37 Studies of probiotic supplementation in animal models and humans showed a reduction in body weight and fat accumulation.38-40 Studies show that probiotic supplements given to mothers prenatally (meaning from at least one month before birth and continuing up to 6 months after birth), subsequently reduced excessive weight gain in the mothers—and their children!41,42
Six Factors Behind Gut Imbalance
 |
The lethal implications for the link between gut imbalance and increased disease risks are clear. But what factors are behind this dangerous imbalance? The answer is that accompanying the rise in a number of diseases in Western societies is the increased influence of a host of factors that continually disrupt our natural gut bacteria balance.
- Antibiotics . One cause of an imbalance between good-to-bad bacteria is the unnecessary use of antibiotics.65 Antibiotic use, even at low sub-therapeutic doses, can disrupt the number and relative proportions of gut bacteria.37
- Infant formula . Common use of infant formula instead of breast milk has interfered with mankind’s long history of transferring bacterial diversity from mother to baby.65,66 Similarly, Caesarian delivery prevents babies from inheriting diverse bacteria from their mothers.65
- Excessive hygiene . An exploding obsession with hygiene has drastically reduced our ability to naturally acquire certain key bacteria from our environment.65
- Western Diet. The Western diet—high in animal proteins and fats, sugars, and refined carbohydrates—causes a rise in undesirable bacteria, not counterbalanced by those that hold them at ideal levels. An example would be a rise in Firmicutes bacteria associated with obesity.37,67 In animals whose digestive tracts were colonized with human bacterial lines, switching from a low-fat, plant polysaccharide-rich diet to a high-fat/high-sugar Western diet adversely shifted the balance of the gut bacteria within a single day.67 Additionally, this dietary shift resulted in changes to metabolic pathways within the gut bacterial ecosystem and altered bacterial gene expression.67 Much of the food in the Western diet is made up of refined carbohydrates, which are absorbed in the upper part of the gastrointestinal tract.68 What eventually reaches the large intestine is of limited value to microbiota in this area because it contains only small amounts of the minerals, vitamins, and other nutrients necessary to maintain them.68 As a result, the numbers and diversity of beneficial intestinal bacteria of modern humans is greatly reduced, compared to the diets of Paleolithic man.68
- Modern Medical Treatments. A number of modern medical treatments are known to severely impair the proper balance of gut bacteria.68 These include artificial ventilation, hygienic measures, use of skin-penetrating devices, tubes and catheters, frequent pharmaceutical use, and more.68
- Age. Recent findings suggest that aging disrupts the bacterial makeup of the gut. This imbalance may contribute to the age-related increase in inflammation known as “inflammaging.”69-71
Cardiovascular disease. In studies conducted on both animals and humans, the use of probiotics decreased total and LDL cholesterol, and increased HDL cholesterol.35,43-45 In addition, recent studies suggest that supplements of beneficial bacteria can reduce cholesterol absorption and the inflammation of fat stores.46,47 These changes contribute to a significant decrease in the formation of inflammatory, cholesterol-laden plaques observed in early atherosclerosis.46,48,49
Cancer. The risk of cancer, particularly of the colon, can be reduced through the use of probiotics.50 Scientists have shown that supplementation with Lactobacillus acidophilus and Bifidobacterium longum significantly decreases the DNA damage that can trigger malignant cell development—confirmed by a reduction in DNA strand-breaking compounds in human feces.18 Replenishing beneficial bacteria with supplements has been found to boost natural antioxidant and detoxification enzymes that prevent the activation of potential dietary carcinogens.50,51
Also, patients with colon cancer and those with pre-cancerous polyps had sharply reduced proliferation of abnormal colon cells and a significant decline in harmful Clostridium bacteria when supplemented with synbiotics (probiotic bacteria combined with prebiotics, which are substances that feed or promote the accompanying bacteria).52
Respiratory infections. Probiotics can significantly suppress respiratory infections such as the common cold and the flu—especially if you begin supplementing prior to cold and flu season.53-56 Studies show that people who supplemented for 3-6 months with different strains of Bifidobacteria and Lactobacillus reduced the duration of symptoms by an average of one to two or even more days, with a similarly impressive reduction in symptom severity.53,54 Two studies in children who were given both Lactobacillus and Bifidobacterium twice daily for 3 to 6 months found a significant decrease in school absenteeism and in the use of antibiotics, as well as reduced symptoms and duration.54,55
Colonization of the nose by potentially pathogenic bacteria, a common complication of colds, was shown to be reduced by 19% with regular probiotic use while the control group showed no change.56 This effect could save the lives of those who are older, or who have a compromised immune system due to chronic disease such as diabetes, or who have recently undergone a major operation—all of whom have a higher risk of being overwhelmed by bacterial infection, particularly those infections affecting the lungs.57-59
The Dangers Of Gut Imbalance
 |
Illness and severe infections are closely associated with significantly reduced and malfunctioning gut bacteria.68 Compared with healthy individuals, critically ill patients often have 10,000 times fewer Bifidobacterium, Lactobacillus, and other bacteria. They also have 100 times more pathogenic (disease-causing) bacteria, such as Staphylococcus.72 Also, organ failure and ICU (intensive care unit) mortality is more common in patients with substantially reduced microbiota populations and diversity combined with the presence of large numbers of enterococci.73
Imbalance and disruption of intestinal flora has been found to impair the body’s ability to maintain the integrity of its mucosal membranes, the protective layers that inhibit pathogens from penetrating the organs and body cavities. As a result, mucosal membranes can no longer prevent the leakage of toxins.68
However, researchers have shown that an imbalance in gut bacteria can be inhibited and even reversed through supplementation with probiotics.74,75
The Importance Of Multiple Species
Although good bacteria can be found in small amounts in food, changing the entire ratio of gut bacteria requires substantial and consistent dosing with supplements providing potent levels of beneficial bacteria to enable their survival.60,61
Two types of probiotic bacteria commonly used include Lactobacillus and Bifidobacterium. There are many specific types of bacteria within each of these two broad groups, and health benefits associated with one type may be unique to that specific species and not hold true for others.62 This means that using multiple different species delivers better odds of reversing the negative effects of dysbacteriosis, a condition where there is an imbalance between good and bad bacteria.63,64
Six Popular Probiotics And Their Specific Disease Benefits
 |
Probiotic supplements have been studied for their effects on an array of disease pathways throughout the body. Although research tying specific probiotic strains and species to particular diseases is still in its infancy, scientists have identified a few disease-treatment benefits for six of the most studied probiotic species:16
Lactobacillus acidophilus
- Reduced diarrhea and improved bowel function in cases of radiation-induced enteritis.
- Increased HDL (good) cholesterol.
- Improved markers for metabolic syndrome, inflammation, and heart disease.
- Improved allergy-driven immune response.
- Improved markers for ulcerative colitis and irritable bowel disease.
- Increased control of blood sugar.17,34
- Decreased the DNA damage that can trigger malignant cell development.18
Lactobacillus rhamnosus
- Reduced diarrhea and improved bowel comfort in cases of radiation-induced enteritis.
- Improved markers for metabolic syndrome, inflammation, and heart disease.
- Reduced allergic response to milk in milk-sensitive patients.
- Improved markers for ulcerative colitis, and irritable bowel disease, including Crohn’s disease.
Lactobacillus paracasei
- Enhanced therapeutic management of Minimal Hepatic Encephalopathy (MHE).
- Improved markers for metabolic syndrome, inflammation, and heart disease in elderly patients.
- Improved markers for ulcerative colitis and irritable bowel disease.
Bifidobacterium lactis
- Improved immune function in healthy, elderly individuals.
- Greater weight gain and less gut inflammation in preterm infants.
- Improved immune response and respiratory symptoms from birch pollen allergies in children.
- Increased control of blood sugar.17,34
Bifidobacterium bifidum
- Improved markers for liver inflammation and damage in alcohol-related liver disease.
- Improved inflammation profiles in ulcerative colitis and irritable bowel disease.
Bifidobacterium longum
- Reduced diarrhea and improved bowel function in cases of radiation-induced enteritis.
- Increased HDL (good) cholesterol.
- Improved markers for ulcerative colitis and irritable bowel disease, including Crohn’s disease.
- Decreased the DNA damage that can trigger malignant cell development.18
Summary
Scientists have shown that prolonged imbalance in intestinal bacteria can do more than induce intestinal or digestive problems—it can trigger numerous chronic diseases outside the intestine!5-11
The link between unbalanced intestinal bacteria and several of today’s most prevalent diseases is clear. However, today’s diet, lifestyle, medical practices, and other factors tend to disrupt gut bacterial balance.2-4
Fortunately, supplementing with key bacterial strains and species counters these destructive influences—restoring your body’s natural, intestine-based protection against a host of non-intestinal diseases!25
If you have any questions on the scientific content of this article, please call a Life Extension® Health Advisor at 1-866-864-3027.
References
- Frick JS, Autenrieth IB. The gut microflora and its variety of roles in health and disease. Curr Top Microbiol Immunol. 2013;358:273-89.
- Ko JS. The intestinal microbiota and human disease. Korean J Gastroenterol. 2013 Aug 25;62(2):85-91.
- Rampelli S, Candela M, Severgnini M, et al. A probiotics-containing biscuit modulates the intestinal microbiota in the elderly. J Nutr Health Aging. 2013 Feb;17(2):166-72.
- Brown K, DeCoffe D, Molcan E, Gibson DL. Diet-induced dysbiosis of the intestinal microbiota and the effects on immunity and disease. Nutrients. 2012 Aug;4(8):1095-119.
- Cox LM, Blaser MJ. Pathways in microbe-induced obesity. Cell Metab. 2013 Jun 4;17(6):883-94.
- Everard A, Cani PD. Diabetes, obesity and gut microbiota. Best Pract Res Clin Gastroenterol. 2013 Feb;27(1):73-83.
- Vyas U, Ranganathan N. Probiotics, prebiotics, and synbiotics: gut and beyond. Gastroenterol Res Pract. 2012;2012:872716.
- Ley RE. Obesity and the human microbiome. Curr Opin Gastroenterol. 2010 Jan;26(1):5-11.
- Sanz Y, Rastmanesh R, Agostonic C. Understanding the role of gut microbes and probiotics in obesity: how far are we? Pharmacol Res. 2013 Mar;69(1):144-55.
- Li DY, Yang M, Edwards S, Ye SQ. Nonalcoholic Fatty Liver Disease: For better or worse, blame the gut microbiota? JPEN J Parenter Enteral Nutr. 2013 Mar 28.
- Mortaz E, Adcock IM, Folkerts G, Barnes PJ, Paul Vos A, Garssen J. Probiotics in the management of lung diseases. Mediators Inflamm. 2013;2013:751068.
- Brown AC, Valiere A. Probiotics and medical nutrition therapy. Nutr Clin Care. 2004 Apr-Jun;7(2):56-68.
- Roberfroid M, Gibson GR, Hoyles L, et al. Prebiotic effects: metabolic and health benefits. Br J Nutr. 2010 Aug;104 Suppl 2:S1-63.
- Guarner F, Malagelada JR. Gut flora in health and disease. Lancet. 2003 Feb 8;361(9356):512-9.
- Furness JB, Kunze WA, Clerc N. Nutrient tasting and signaling mechanisms in the gut. II. The intestine as a sensory organ: neural, endocrine, and immune responses. Am J Physiol. 1999 Nov;277(5 Pt 1):G922-8.
- Hakansson A, Molin G. Gut microbiota and inflammation. Nutrients. 2011 June; 3(6):637-82.
- Ejtahed HS, Mohtadi-Nia J, Homayouni-Rad A, Niafar M, Asghari-Jafarabadi M, Mofid V. Probiotic yogurt improves antioxidant status in type 2 diabetic patients. Nutrition. 2012 May;28(5):539-43.
- Oberreuther-Moschner DL, Jahreis G, Rechkemmer G, Pool-Zobel BL. Dietary intervention with the probiotics Lactobacillus acidophilus 145 and Bifidobacterium longum 913 modulates the potential of human faecal water to induce damage in HT29clone19A cells. Br J Nutr. 2004 Jun;91(6):925-32.
- Yan F, Cao H, Cover TL, Whitehead R, Washington MK, Polk DB. Soluble proteins produced by probiotic bacteria regulate intestinal epithelial cell survival and growth. Gastroenterology. 2007 Feb;132(2):562-75.
- Kotzamanidis C, Kourelis A, Litopoulou-Tzanetaki E, Tzanetakis N, Yiangou M. Evaluation of adhesion capacity, cell surface traits and immunomodulatory activity of presumptive probiotic Lactobacillus strains. Int J Food Microbiol. 2010 Jun 15;140(2-3):154-63.
- Kumar M, Kumar A, Nagpal R, et al. Cancer-preventing attributes of probiotics: an update. Int J Food Sci Nutr. 2010 Aug;61(5):473-96.
- de Moreno de LeBlanc A, Matar C, Perdigon G. The application of probiotics in cancer. Br J Nutr. 2007 Oct;98 Suppl 1:S105-10.
- Soltan Dallal MM, Yazdi MH, Holakuyee M, Hassan ZM, Abolhassani M, Mahdavi M. Lactobacillus casei ssp.casei induced Th1 cytokine profile and natural killer cells activity in invasive ductal carcinoma bearing mice. Iran J Allergy Asthma Immunol. 2012 Jun;11(2):183-9.
- Magrone T, Jirillo E. The interplay between the gut immune system and microbiota in health and disease: nutraceutical intervention for restoring intestinal homeostasis. Curr Pharm Des. 2013;19(7):1329-42.
- de Vrese M, Schrezenmeir J. Probiotics, prebiotics, and synbiotics. Adv Biochem Eng Biotechnol. 2008;111:1-66.
- Sivieri K, Villarreal ML, Adorno MA, Sakamoto IK, Saad SM, Rossi EA. Lactobacillus acidophilus CRL 1014 improved “gut health” in the SHIME(R) reactor. BMC Gastroenterol. 2013 Jun 11;13(1):100.
- Kaur IP, Kuhad A, Garg A, Chopra K. Probiotics: delineation of prophylactic and therapeutic benefits. J Med Food. 2009 Apr;12(2):219-35.
- Ouwehand AC, Tiihonen K, Saarinen M, Putaala H, Rautonen N. Influence of a combination of Lactobacillus acidophilus NCFM and lactitol on healthy elderly: intestinal and immune parameters. Br J Nutr. 2009 Feb;101(3):367-75.
- Buzas GM. Probiotics in gastroenterology -- from a different angle. Orv Hetil. 2013 Feb 24;154(8):294-304.
- Kondo J, Xiao JZ, Shirahata A, et al. Modulatory effects of Bifidobacterium longum BB536 on defecation in elderly patients receiving enteral feeding. World J Gastroenterol. 2013 Apr 14;19(14):2162-70.
- Guyonnet D, Schlumberger A, Mhamdi L, Jakob S, Chassany O. Fermented milk containing Bifidobacterium lactis DN-173 010 improves gastrointestinal well-being and digestive symptoms in women reporting minor digestive symptoms: a randomised, double-blind, parallel, controlled study. Br J Nutr. 2009 Dec;102(11):1654-62.
- Ringel-Kulka T, Palsson OS, Maier D, et al. Probiotic bacteria Lactobacillus acidophilus NCFM and Bifidobacterium lactis Bi-07 versus placebo for the symptoms of bloating in patients with functional bowel disorders: a double-blind study. J Clin Gastroenterol. 2011 Jul;45(6):518-25.
- Bixquert Jiménez M. Treatment of irritable bowel syndrome with probiotics. An etiopathogenic approach at last? Rev Esp Enferm Dig. 2009 Aug;101(8):553-64.
- Esteve E, Ricart W, Fernández-Real JM. Gut microbiota interactions with obesity, insulin resistance and type 2 diabetes: did gut microbiote co-evolve with insulin resistance? Curr Opin Clin Nutr Metab Care. 2011 Sep;14(5):483-90.
- Moroti C, Souza Magri LF, de Rezende Costa M, Cavallini DC, Sivieri K. Effect of the consumption of a new symbiotic shake on glycemia and cholesterol levels in elderly people with type 2 diabetes mellitus. Lipids Health Dis. 2012;11:29.
- Hsieh FC, Lee CL, Chai CY, Chen WT, Lu YC, Wu CS. Oral administration of Lactobacillus reuteri GMNL-263 improves insulin resistance and ameliorates hepatic steatosis in high fructose-fed rats. Nutr Metab (Lond). 2013;10(1):35.
- Million M, Lagier JC, Yahav D, Paul M. Gut bacterial microbiota and obesity. Clin Microbiol Infect. 2013 Apr;19(4):305-13.
- Kadooka Y, Sato M, Imaizumi K, et al. Regulation of abdominal adiposity by probiotics (Lactobacillus gasseri SBT2055) in adults with obese tendencies in a randomized controlled trial. Eur J Clin Nutr. 2010 Jun;64(6):636-43.
- Park DY, Ahn YT, Park SH, et al. Supplementation of Lactobacillus curvatus HY7601 and Lactobacillus plantarum KY1032 in diet-induced obese mice is associated with gut microbial changes and reduction in obesity. PLoS One. 2013;8(3):e59470.
- Yoo SR, Kim YJ, Park DY, et al. Probiotics L. plantarum and L. curvatus in combination alter hepatic lipid metabolism and suppress diet-induced obesity. Obesity (Silver Spring). 2013 Mar 20.
- Luoto R, Kalliomaki M, Laitinen K, Isolauri E. The impact of perinatal probiotic intervention on the development of overweight and obesity: follow-up study from birth to 10 years. Int J Obes (Lond). 2010 Oct;34(10):1531-7.
- Ilmonen J, Isolauri E, Poussa T, Laitinen K. Impact of dietary counselling and probiotic intervention on maternal anthropometric measurements during and after pregnancy: a randomized placebo-controlled trial. Clin Nutr. 2011 Apr;30(2):156-64.
- Tomaro-Duchesneau C, Saha S, Malhotra M, et al. Effect of orally administered L. fermentum NCIMB 5221 on markers of metabolic syndrome: an in vivo analysis using ZDF rats. Appl Microbiol Biotechnol. 2013 Oct 13.
- Ejtahed HS, Mohtadi-Nia J, Homayouni-Rad A, et al. Effect of probiotic yogurt containing Lactobacillus acidophilus and Bifidobacterium lactis on lipid profile in individuals with type 2 diabetes mellitus. J Dairy Sci. 2011 Jul;94(7):3288-94.
- Kumar M, Nagpal R, Kumar R, et al. Cholesterol-lowering probiotics as potential biotherapeutics for metabolic diseases. Exp Diabetes Res. 2012;2012:902917.
- Mencarelli A, Cipriani S, Renga B, et al. VSL#3 resets insulin signaling and protects against NASH and atherosclerosis in a model of genetic dyslipidemia and intestinal inflammation. PLoS One. 2012;7(9):e45425.
- Yoon HS, Ju JH, Kim HN, et al. Reduction in cholesterol absorption in Caco-2 cells through the down-regulation of Niemann-Pick C1-like 1 by the putative probiotic strains Lactobacillus rhamnosus BFE5264 and Lactobacillus plantarum NR74 from fermented foods. Int J Food Sci Nutr. 2013 Feb;64(1):44-52.
- Mohania D, Kansal VK, Shah D, et al. Therapeutic effect of probiotic dahi on plasma, aortic, and hepatic lipid profile of hypercholesterolemic rats. J Cardiovasc Pharmacol Ther. 2013 May 12.
- Cavallini DC, Suzuki JY, Abdalla DS, et al. Influence of a probiotic soy product on fecal microbiota and its association with cardiovascular risk factors in an animal model. Lipids Health Dis. 2011;10:126.
- Stein K, Borowicki A, Scharlau D, et al. Effects of synbiotic fermentation products on primary chemoprevention in human colon cells. J Nutr Biochem. 2012 Jul;23(7):777-84.
- Verma A, Shukla G. Probiotics Lactobacillus rhamnosus GG, Lactobacillus acidophilus suppresses DMH-induced procarcinogenic fecal enzymes and preneoplastic aberrant crypt foci in early colon carcinogenesis in Sprague Dawley rats. Nutr Cancer. 2013;65(1):84-91.
- Rafter J, Bennett M, Caderni G, et al. Dietary synbiotics reduce cancer risk factors in polypectomized and colon cancer patients. Am J Clin Nutr. 2007 Feb;85(2):488-96.
- Pregliasco F, Anselmi G, Fonte L, Giussani F, Schieppati S, Soletti L. A new chance of preventing winter diseases by the administration of synbiotic formulations. J Clin Gastroenterol. 2008 Sep;42 Suppl 3 Pt 2:S224-33.
- Leyer GJ, Li S, Mubasher ME, Reifer C, Ouwehand AC. Probiotic effects on cold and influenza-like symptom incidence and duration in children. Pediatrics. 2009 Aug;124(2):e172-9.
- Rerksuppaphol S, Rerksuppaphol L. Randomized controlled trial of probiotics to reduce common cold in schoolchildren. Pediatr Int. 2012 Oct;54(5):682-7.
- Gluck U, Gebbers JO. Ingested probiotics reduce nasal colonization with pathogenic bacteria (Staphylococcus aureus, Streptococcus pneumoniae, and beta-hemolytic streptococci). Am J Clin Nutr. 2003 Feb;77(2):517-20.
- Hamilton EJ, Martin N, Makepeace A, Sillars BA, Davis WA, Davis TM. Incidence and predictors of hospitalization for bacterial infection in community-based patients with type 2 diabetes: the fremantle diabetes study. PLoS One. 2013;8(3):e60502.
- Weiskopf D, Weinberger B, Grubeck-Loebenstein B. The aging of the immune system. Transpl Int. 2009 Nov;22(11):1041-50.
- Available at: http://www.lung.org/lung-disease/pneumonia/understanding-pneumonia.html. Accessed October 17, 2013.
- Available at: http://probiotics.org/probiotic-foods. Accessed October 17, 2013.
- Elizabeth C. Verna Use of probiotics in gastrointestinal disorders: what to recommend? Therap Adv Gastroenterol. 2010 Sep;3(5): 307–19.
- Available at: http://nccam.nih.gov/health/probiotics/introduction.htm. Accessed October 17, 2013.
- Chapman CM, Gibson GR, Rowland I. Health benefits of probiotics: are mixtures more effective than single strains? Eur J Nutr. 2011 Feb;50(1):1-17.
- Chapman CM, Gibson GR, Rowland I. In vitro evaluation of single- and multi-strain probiotics: Inter-species inhibition between probiotic strains, and inhibition of pathogens. Anaerobe. 2012 Aug;18(4):405-13.
- Van den Abbeele P, Verstraete W, El Aidy S, Geirnaert A, Van de Wiele T. Prebiotics, faecal transplants and microbial network units to stimulate biodiversity of the human gut microbiome. Microb Biotechnol. 2013 Jul;6(4):335-40.
- Penders J, Vink C, Driessen C, London N, Thijs C, Stobberingh EE. Quantification of Bifidobacterium spp., Escherichia coli and Clostridium difficile in faecal samples of breast-fed and formula-fed infants by real-time PCR. FEMS Microbiol Lett. 2005;243:141-7.
- Turnbaugh PJ, Ridaura VK, Faith JJ, Rey FE, Knight R, Gordon JI. The effect of diet on the human gut microbiome: a metagenomic analysis in humanized gnotobiotic mice. Sci Transl Med. 2009 Nov 11;1(6):6ra14.
- Bengmark S. Nutrition of the critically ill—A 21st-century perspective. Nutrients. 2013 January; 5(1):162-207.
- Claesson MJ, Jeffery IB, Conde S, et al. Gut microbiota composition correlates with diet and health in the elderly. Nature. 2012 Aug 9;488(7410):178-84.
- Jeffery IB, O’Toole PW. Diet-microbiota interactions and their implications for healthy living. Nutrients. 2013 Jan;5(1):234-52.
- Rehman T. Role of the gut microbiota in age-related chronic inflammation. Endocr Metab Immune Disord Drug Targets. 2012 Dec;12(4):361-7.
- Shimizu K, Ogura H, Goto M, et al. Altered gut flora and environment in patients with severe SIRS. J Trauma. 2006 Jan;60(1):126-33.
- Iapichino G, Callegari ML, Marzorati S, Cigada M, Corbella D, Ferrari S, Morelli L. Impact of antibiotics on the gut microbiota of critically ill patients. J Med Microbiol. 2008;57:1007-14.
- Gao XW, Mubasher M, Fang CY, Reifer C, Miller LE. Dose-response efficacy of a proprietary probiotic formula of Lactobacillus acidophilus CL1285 and Lactobacillus casei LBC80R for antibiotic-associated diarrhea and Clostridium difficile-associated diarrhea prophylaxis in adult patients. Am J Gastroenterol. 2010 Jul;105(7):1636-41.
- Lawley TD, Clare S, Walker AW, et al. Targeted restoration of the intestinal microbiota with a simple, defined bacteriotherapy resolves relapsing Clostridium difficile disease in mice. PLoS Pathog. 2012;8(10):e1002995.

